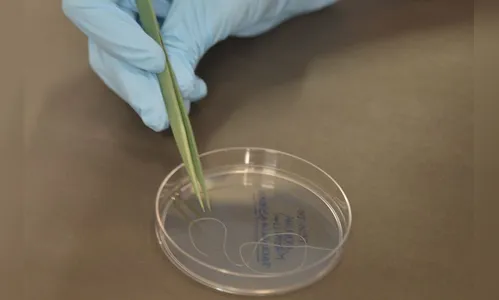
Veja o que Bolsonaro e Haddad propõem para ciência e tecnologia

Veja o que Bolsonaro e Haddad propõem para ciência e tecnologia

Receba notícias no seu Whatsapp Participe dos grupos do TNOnline
Os programas para a área de Ciência, Tecnologia e Inovação dos candidatos Jair Bolsonaro (PSL) e Fernando Haddad (PT) apresentam ênfases diferentes no tocante às prioridades e ao papel do Estado e do governo federal. Nos dois planos de governo, há seções específicas para o tema, que aparecem junto com desafios de desenvolvimento econômico e à estruturação do ensino superior.
Jair Bolsonaro condena o que chama de “centralização em Brasília” e propõe o estímulo a polos descentralizados nos quais haveria parceria entre universidades e a iniciativa privada. Enquanto o programa de Haddad defende uma retomada de investimentos públicos em pesquisa, especialmente por meio da Coordenação de Aperfeiçoamento de Pessoal de Nível Superior (Capes) e do Conselho Nacional de Desenvolvimento Científico e Tecnológico (CNPq).
Em relação à estrutura responsável, os dois candidatos mencionam um ministério específico para a área. Fernando Haddad (PT) fala na recriação do Ministério da Ciência, Tecnologia e Inovação (MCTI), desmembrando o atual MCTIC, criado após a fusão da antiga pasta com a das Comunicações. No programa de Bolsonaro, há uma proposta de cortar o número de ministérios para 15. O documento não traz a listagem de quais seriam estes. Em entrevistas à imprensa, o candidato chegou a mencionar a indicação do astronauta Marcos Pontes para comandar o ministério.

Jair Bolsonaro (PSL)
O plano do candidato avalia que o modelo de pesquisa e inovação no Brasil está “esgotado”. A área não deveria ser baseada em uma estratégia centralizada, organizada por Brasília e centrada em recursos públicos. No lugar, defende o fomento de “hubs” tecnológicos nos quais universidades se aliam à iniciativa privada “para transformar ideias em produtos”. O texto cita experiências de países como Japão e Coreia do Sul, advogando por um foco nas ciências exatas.
O programa coloca a necessidade de se criar um ambiente favorável ao empreendedorismo no Brasil, com estímulo a que alunos busquem abrir negócios próprios. Quem deseja seguir carreira acadêmica deve fazê-lo em programas de mestrado e doutorado “sempre perto das empresas”. O documento defende que o campo da ciência não deve ser “estéril”. O texto indica a busca de especificidades em cada região, citando como exemplo a exploração de energia renovável solar e eólica no Nordeste.
Outra proposta é que o país invista na pesquisa e desenvolvimento em grafeno e nióbio. O primeiro é uma forma cristalina do carbono, forte, leve e bom condutor. O nióbio é usado em ligas de aço. No capítulo sobre economia, o programa prevê a abertura comercial para importação de equipamentos para a migração para a indústria 4.0, requalificação de mão-de-obra para tecnologias de ponta e apoio a startups (pequenas empresas de tecnologia).
Nas propostas para segurança, elenca investimento em equipamentos e tecnologia, entre outros itens. Ao tratar da Defesa Nacional, o texto prevê que as Forças Armadas precisam de equipamentos modernos diante das ameaças digitais. Essas instituições precisariam estar preparadas por meio de pesquisa e desenvolvimento tecnológico.
Últimas em Cotidiano
Mais lidas no TNOnline

Últimas do TNOnline











